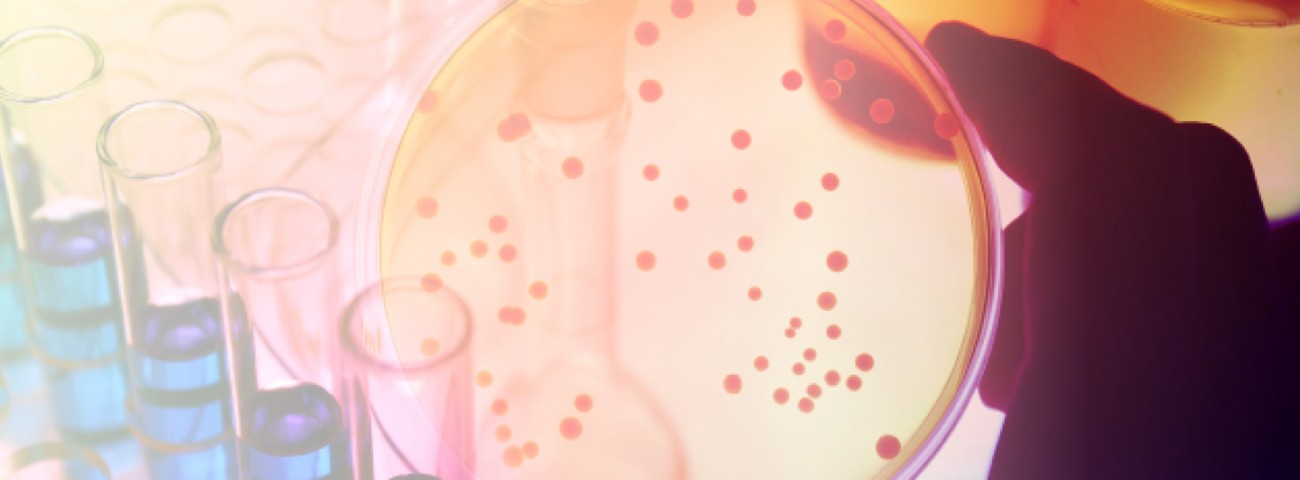
Informations scientifiques

WAS WIR FÜR PATIENTINNEN UND PATIENTEN TUN
Unsere diagnostische Arbeit macht den entscheidenden Unterschied aus – für Millionen von Menschen, Tag für Tag.
Was wir für medizinische Fachpersonen tun
Wir bieten in fünfzehn Ländern branchenführende labormedizinische, bildgebende und pathologische Diagnostikdienstleistungen an.